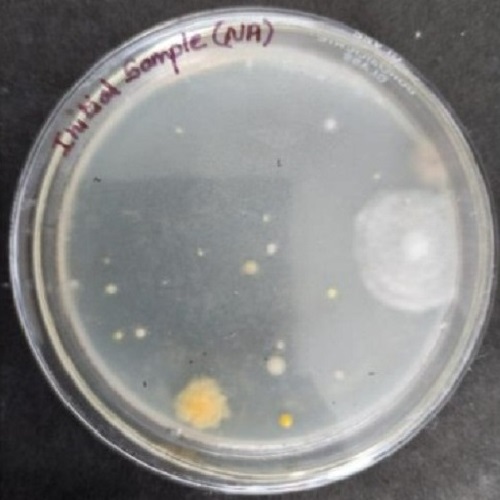
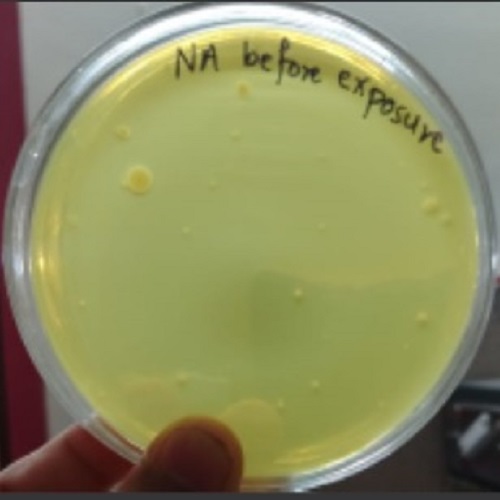
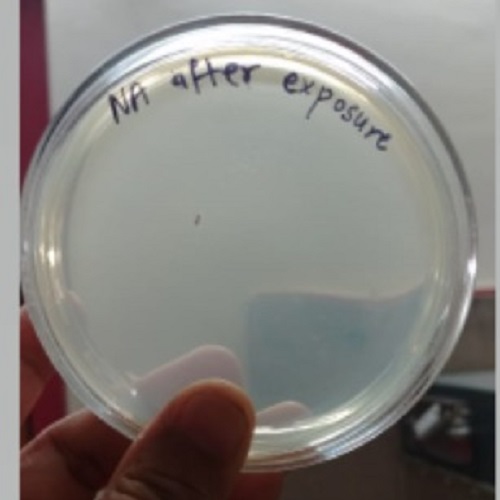

Detection > Disinfection

Suraxa® Biosensor & Bio-aerosol Disinfection System
A patent pending innovation, devoid of any external chemicals & proven to kill pathogens associated with Hospital Acquired Infections (HAI).
Bioaerosol infections in Hospital environments are a serious issue.
Target Areas prone to HAI infection -
- 1.ICU
- 2.ICCU
- 3.Operation Theater
- 4.Cath Labs
- 5.Respiratory Ward
- 6.TB Ward
- 7.Burn Ward
- 8.Diagnostic Labs
- 9.Microbiology Labs
Measurement & Control Technology

Measurement

Disinfection Process
Proof Of Concept (POC)
Pre-Disinfection and Post-Disinfection with Suraxa® Bsafe
Proof of Concept at Shri Lakshmi Hospital, Pune
Pre-Disinfection

Post-Disinfection
Proof of Concept at Imax Hospital, Pune
Pre-Disinfection
Post-Disinfection
Successfully Tested Against
- Drug-resistant pathogens
- Fungi
- Spores
All Rights Reserved © PIPL, 2023